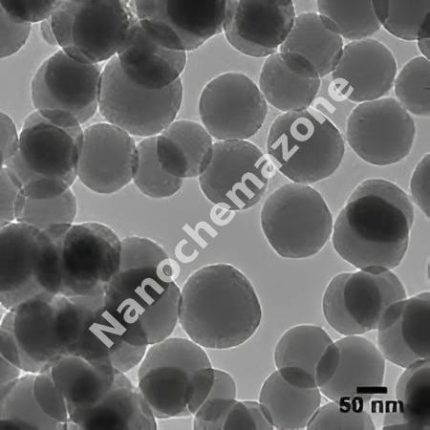
H-MCM-48(All Si) (883853)

H-ZSM-5 (293853) Description:
H-ZSM-5 (293853) is one of the numerous advanced ceramic materials manufactured by Nanochemazone. Nanochemazone produces too many standard grades when applicable, including Mil Spec (military grade); ACS, Reagent and Technical Grade; Food, Agricultural and Pharmaceutical Grade; Optical Grade, USP and EP/BP (European Pharmacopoeia/British Pharmacopoeia) and follows applicable ASTM testing standards. Typical and custom packaging is available. Additional technical, research and safety (MSDS) information are available. Please request a quote above for more information on lead time and pricing.
H-ZSM-5 (293853) Information:
Storage Conditions:
Airtight sealed, avoid light and keep dry at room temperature.
Please contact us for customization and price inquiry
Email: contact@nanochemazone.com
Note: We supply different size ranges of Nano and micron as per the client’s requirements and also accept customization in various parameters.